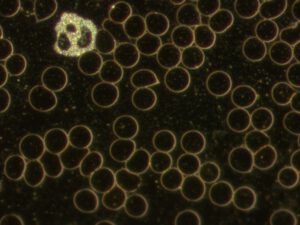
Dunkelfeld-Bilder aus der Praxis

Mag. Robert Haas widmet sich in seiner Praxis der Wiederherstellung des energetischen Gleichgewichts im Körper – mit Methoden wie Bioresonanz und Dunkelfeld-Mikroskopie. Sein Ansatz verbindet Erfahrung, Präzision und ganzheitliches Denken: Ziel ist es, Blockaden zu erkennen, die Selbstheilungskräfte zu aktivieren und so die natürliche Regulation des Körpers zu fördern.
Im Gespräch erklärt Robert Haas, wie er mit bioenergetischen Verfahren arbeitet, warum die Kombination aus Analyse und energetischer Unterstützung so wirkungsvoll sein kann – und wie er Menschen hilft, ihre Gesundheit nachhaltig zu stärken.
Interview mit Mag. Robert Haas
Sie arbeiten mit Verfahren wie Bioresonanz, Dunkelfeld-Mikroskopie und Elektroakupunktur nach Voll – wie kombinieren Sie diese Methoden, und was macht Ihren Ansatz besonders wirksam?
Die Methode EAV nach Dr. Voll verwende ich nicht mehr, da sie nicht wirklich Vorteile gebracht hat, und schwieriger durchzuführen ist als Bioresonanz.
Ich arbeite mit den beiden Verfahren Bioresonanz und Dunkelfeld-Mikroskopie jeweils meistens getrennt.
Bioresonanz ist ein bioenergetisches Verfahren.
Das Konzept der Bioresonanz basiert auf der Annahme, dass jede Materie – also auch der menschliche Körper und alle seine Bestandteile – bis in die kleinsten Strukturen, einzigartige elektromagnetische Schwingungsmuster aussendet. Jedes Organ und sogar Umweltgifte und Erreger haben demnach ein eigenes Frequenzmuster.“
Energetische Disharmonien, welche das energetische Gleichgewicht und die Selbstheilungskräfte des Körpers blockieren können, sind auf der Bioenergetischen Ebene testbar“.
Bioresonanz kann den Körper dabei unterstützen, sein energetisches Gleichgewicht wiederzufinden.
Im der nachfolgenden Graphik der WKO ist die Bioenergetische Ebene auch als feinstoffliche Ebene dargestellt.

Grundlage der Bioresonanz-Theorie
Alles was im Universum vorhanden ist, hat eine eigene elektromagnetische Schwingung.
Diese Schwingung kann in Bioresonanz-Ampullen abgebunden werden und auf den Körper des Klienten geschwungen werden. Dadurch entsteht im Körper des Klienten entweder eine Resonanz oder keine Resonanz, denn der Körper geht immer mit seiner Umwelt in Resonanz.
Jedes gesunde Organ hat eine eigene elektromagnetische Schwingung. Jedes geschwächte Organ hat eine davon abweichende elektromagnetische Schwingung. Auch jede Substanz hat eine eigene Schwingung. Toxine z.B. schädigen die Eigenschwingungen der Organe, und können energetische Regulationsmechanismen schwächen bzw. blockieren, um es einfach darzustellen. Durch eine Toxinbelastung eines Organs kann daher die Eigenschwingung des Organs verändert werden. Diese Veränderung würde dann bei entsprechender bioenergetischer Testung als Resonanz testen.
Durch die Tatsache, dass alles eine eigene Schwingung hat, kann mit der Bioresonanz-Methode getestet werden, ob das energetische Gleichgewicht der Meridiane und Organe gesund ist oder nicht.
Erläuterung
Da diese Impulse sehr schwach sind, sind sie von herkömmlichen Messgeräten nicht erfassbar. Aus diesem Grund wird die Existenz dieser Frequenzmuster und damit die Wirkungsweise der Bioresonanz nicht wissenschaftlich anerkannt. Die Medizin fordert für die Anerkennung eines Verfahrens den Nachweis seiner Wirksamkeit in doppelblinden, placebokontrollierten Studien. Diesen Nachweis konnte die Bioresonanz bisher nicht erbringen. Die feinen elektromagnetischen Impulse, welche die Grundlage der Methode bilden, sind mit den gängigen Messgeräten nicht erfassbar. Die Bioresonanz beruht also auf der Erfahrung der Anwender, deren Wirkung sich in der Praxis zeigt und die von vielen Menschen als eine wertvolle Ergänzung zu anderen Therapien erlebt wird.
Dunkelfeld-Mikroskopie
Die Dunkelfeldmikroskopie dient als wertvolles Begleitinstrument in der ganzheitlichen energetischen Analyse von Regulationsmechanismen und der Säure-Basen-Balance. Sie kann eigenständig durchgeführt werden und bedarf keinem weiteren Verfahren.
Die Dunkelfeldmikroskopie dient in meiner Praxis dazu, Zusammenhänge der körperlichen Regulation sichtbar zu machen. Die gewonnenen Hinweise sind eine wichtige Grundlage für:
– Individuelle Empfehlungen: Ableitung gezielter Regulationsmaßnahmen wie Anpassung der Lebensgewohnheiten, Entsäuerung, Ausleitung & Entgiftung
– Transparenz und Motivation: Die Live-Beobachtung des eigenen Milieus schafft eine aktive Auseinandersetzung mit der eigenen Gesundheit. Dies kann bei manchen Klienten die Motivation verstärken, gesundheitliche Maßnahmen umzusetzen
– Verlaufskontrolle: Ein Kontrolltermin erlaubt eine visuelle Beurteilung, ob die eingeleiteten Maßnahmen zu einer Verbesserung der körperlichen Regulation und der Säure-Basen-Balance geführt haben.
Hinweis: Die Dunkelfeldanalyse ist keine Voraussetzung für die Bioresonanz-Methode – es handelt sich um voneinander getrennte Verfahren. Die Bioresonanz-Testung und Therapie erlaubt eine spezifischere Analyse der energetischen Situation.
Mit der Dunkelfeld-Mikroskopie sieht man die qualitative Beschaffenheit der Blutzellen im Dunkelfeld-Mikroskop.
Dieses Bild gibt vorrangig Auskunft über die Säure-Basen-Balance und die Regulationsfähigkeit des Körpers. Je übersäuerter ein Klient ist, desto stärker sind die Abweichungen des zu analysierenden Bluttropfens zu einem schönen unbelasteten Bild, wie Sie nachfolgend sehen können. Diese Abweichung können alle Blutbestandteile betreffen.
An den nächsten beiden Bildern sehen Sie den Unterschied zwischen einem gesunden Blut und einem leicht belasteten Blut.
Bild eines unbelasteten gesunden Blutstropfens im Dunkelfeld-Mikroskop

Bild eines leicht belasteten und übersäuerten Blutstropfens im Dunkelfeld-Mikroskop
Folgende weitere Informationen über den energetischen Zustand eines Klienten können aus der Blutanalyse durch Beobachtung der Blutzellen gewonnen werden:
- Form und Aktivität der roten und weißen Blutkörperchen
- Geldrollen-Bildung (gestörte Fließeigenschaften des Blutes)
- Energiemangel
- Ausleitungsstörungen
- Eiweißüberlastung, Übersäuerung
Rechtlicher Hinweis zur Dunkelfeld-Mikroskopie
In Österreich fällt die Anwendung der Dunkelfeldmikroskopie in den Bereich des freien Gewerbes und dient der energetischen Dokumentation. Die Dunkelfeldmikroskopie nach Enderlein ist wissenschaftlich nicht anerkannt und zählt nicht zu den anerkannten Methoden der klassischen Medizin.
– Mit dieser Methode kann keine schulmedizinische Diagnose erstellt und es kann nicht auf Krankheiten geschlossen werden
– Diese Analyse ersetzt keinesfalls eine ärztliche Untersuchung oder klassische Laborbefunde. Bei Beschwerden ist stets der Rat und die Behandlung durch einen Arzt einzuholen.
Für viele ist Bioresonanz noch ein eher unbekannter Begriff. Wie erklären Sie Ihren Klient:innen diese Methode – und was ist ihr zentrales Wirkprinzip?
Ziel jeder Bioresonanz-Therapie ist die „Wiederherstellung des energetischen Gleichgewichts“.
Wenn dieses wiederhergestellt ist und die Energieblockaden abgebaut wurden, können, wenn keine anderen Regulationsblockaden vorliegen, die Selbstheilungskräfte die Gesundheit im Körper wieder herstellen.
Da ich meine Klienten auf dem schnellstmöglichen Weg in die Wiederherstellung des energetischen Gleichgewichts führen möchte und ihre Selbstheilungskräfte stärken möchte, sind für mich noch andere gesundheitliche Faktoren wichtig, wo meine Klienten Empfehlungen zur Stärkung ihrer Gesundheit erhalten.
Diese sind:
- Gesunde Ernährung
- Weglassen von allgemein schädlichen Nahrungsmitteln & Karenzierung von Nahrungsmittel-Allergenen bzw. -Unverträglichkeiten
- Spezifische Ernährung zur Sanierung eines gestörten Darmmilieus
- Gezielte Nährstoffsupplementierung zum Ausgleich von Mangelzuständen und Organunterstützung
- Gesundes und richtiges Trinkverhalten
- Schutz vor Elektrosmog und Erdung
- Entsäuerungsmaßnahmen zur Wiederherstellung der Säure-Basen-Balance
- Stressabbau und Stressmanagement
- Wiederherstellung eines guten und tiefen Schlafes
- Regelmäßige Bewegung
- Richtige Pflege
- Ausleitung von Toxinen
Gerade durch diese individuellen Gesundheitssteigerungs-Maßnahmen können bei vielen Klienten positive gesundheitliche Effekte erzielt werden.
Zum besseren Verständnis:
Bioresonanz ist nicht gleich Bioresonanz
Wenn Sie eintausend verschiedene Therapeuten vergleichen, werden sie bemerken, dass alle eintausend Therapeuten unterschiedlich arbeiten.
Diese Unterschiede kommen vom Grad des Ausbildungsstandes und der Weiterbildung und vom gesundheitlichen Spezialwissen, das viele Bereiche betrifft.
Weiters sind die empfohlenen Maßnahmen für den Therapieerfolg entscheidend und ob nach einem „übergeordneten Therapieplan“ vorgegangen wird oder nicht.
Das verwendete Bioresonanz Gerät und ob mit einem digitalen oder analogen System gearbeitet wird, kann auch Unterschiede im Therapieerfolg bewirken.
Die Methodenwahl richtet sich nach Beschwerden wie Erschöpfung, Unverträglichkeiten oder Hautproblemen. Wie wählen Sie die passenden Verfahren – und wie messen Sie den Erfolg?
Denn mittels Bioresonanz kann ich analysieren, welche Ursachen zu den gesundheitlichen Störungen geführt haben.
Dunkelfeld-Mikroskopie empfehle ich dann, wenn der Säure-Basen-Haushalt, Eiweißüberlastung oder Ausleitungsstörungen analysiert werden sollen.
Der Erfolg der Behandlung wird durch ein Gespräch mit dem Klienten über allfällige Verbesserungen in der Körperenergie und dem Wohlbefinden und mittels Bioresonanz bei zu therapierenden Themen bei jeder Bioresonanz-Sitzung überprüft.
Bei der Dunkelfeld-Mikroskopie wird der Therapie-Erfolg ebenfalls über ein Gespräch mit dem Klienten ermittelt und dann live mit dem Dunkelfeld-Mikroskop überprüft.
Mag. Robert Haas: Selbstheilungsprozesse begleiten

Wie begleiten Sie den Selbstheilungsprozess bei chronischen Belastungen oder Stoffwechselstörungen?
Chronische Belastungen z.B. von Toxinen unterstütze ich mich geeigneten Ausleitungs- und Bindemitteln. Dabei beziehe ich die Art der Toxine und den Ort der Toxinablagerung in die Analyse und die Auswahl der richtigen Mittel ein. Ausleitungsmitteln in Form von Darmbindemittel empfehle ich fast allen Klienten, denn Toxine sollten im Darm gebunden und nicht mit dem Gallensaft im unteren Dünndarm in die Leber rückresorbiert werden.
Durch Bindung und Ausleitung von Toxinen werden die Selbstheilungskräfte gestärkt.
Stoffwechselstörungen kommen eher selten vor und müssen von einem Arzt diagnostiziert und behandelt werden.
Klienten haben sehr oft energetische Schwächen in Organen wie der Leber und den Nieren oder dem Bindegewebe, was zu Ausscheidungsblockaden führen kann. Hier empfehle ich zuerst eine gezielte Leberaufbau- bzw. Nierenstabilisierungstherapie und Toxinbindung und spezielle Entsäuerungsmaßnahmen.
Wenn Sie Stoffwechselprobleme als Problem beim Gewichtsverlust verstehen, wird diese meistens von den folgenden Faktoren verursacht:
- Stressbelastung inkl. eines hohen Cortisolspiegels
- Energetische Leberbelastung
- Übersäuerung der Organe und des Bindegewebes
- Bewegungsmangel
- Falsche Ernährung mit zu wenig Vitalstoffen, zu hohem Auszugsmehl- und zu hohem Zucker- und Fettverzehr
Sie sprechen auch Umweltbelastungen wie Schwermetalle oder Gifte an. Wie gehen Sie bei der Aufdeckung und Behandlung solcher Belastungen systematisch vor?
Umwelttoxine können in geringem Umfang mit Bioresonanz getestet werden. Es gibt ca. 3000 Umweltgifte. Davon kommen wir Menschen im modernen Leben mit ca. 200 Toxinen in Kontakt.
Wenige davon wie z.B. Schwermetalle und Pestizide kann ich mittels Bioresonanz testen und eine Ausleitung dieser Stoffe aus dem Bindegewebe, Fettgewebe und den Organen fördern.
Können Sie ein Beispiel nennen, bei dem Ihr ganzheitlicher Ansatz bei einer Klientin oder einem Klienten spürbar zur Verbesserung der Lebensqualität beigetragen hat?
Eine 33 jährige Klientin hatte seit vielen Jahren starke gesundheitliche Probleme:
- Viele Unverträglichkeiten – sie musste beim Essen sehr aufpassen und konnte nur sehr wenige Lebensmitteln essen. Essen hat sie generell wegen den vielen Unverträglichkeiten stark belastet., weil sie nie wusste, welche Reaktionen entstehen werden
- Zuckersucht
- Candida Belastung + Juckreiz am After
- Brainfog
- Angeschwollene Lymphbahnen unter den Achseln
- Allergisches Asthma seit 5 Jahren
- Starke Elektrosmog-Empfindlichkeit (Elektroauto-Auto, Induktionsherd)
- Bis vor 10 Jahren viele Jahre keine Energie gehabt – oft nicht aufstehen können
Bei einer Bioresonanz-Testung wurden folgende energetische Disharmonien festgestellt:
- Sehr starke Stressbelastung inkl. Nebennierenschwäche und Aktivierung von Stressachsen ins Gehirn, ins Nervensystem und auf die Nebennieren
- Energetische Schwäche im Immunsystem
- Allergie Miasma
- Allergie auf Histamin, Soja, Weizen, Gluten, Mais, Mandeln, Erdnüsse
- Viele Unverträglichkeiten: u.a. auf Histamin, Kuhmilch, Hefe, Weizen, Safran, Pökelstoff, Glutamat, Xylit, Hirse, Süßholz, Mannit, Sacharin, Sorbit, Maltitol
- Energetische Darmfloraschwäche
- Energetische Schwäche der Verdauungsorgane Dünndarm, Dickdarm, Magen, Pankreas
- Energetische Schwäche der Leber, der Nieren, des Lymphsystems
- Ursachen:
- Elektrosmog Belastung
- Stressbelastung, die negativ auf das Immunsystem, den Darm und die Entgiftung wirkt
- Erregerbelastungen
- Mikronährstoffmangel
Nach der Durchführung von Bioresonanz-Therapie Sitzungen zur energetischen Stabilisation alle 3-4 Wochen und der Beseitigung der Mikronährstoffmängel unter Berücksichtigung des übergeordneten Therapieplans für die letzten beiden Jahre ist diese Klientin wieder stark, hat viel Energie und kann alles essen und daher ihr Leben wieder genießen.
Ihre beiden Eltern haben auch schon meine Praxis besucht und sind in erfolgreicher Therapie.





